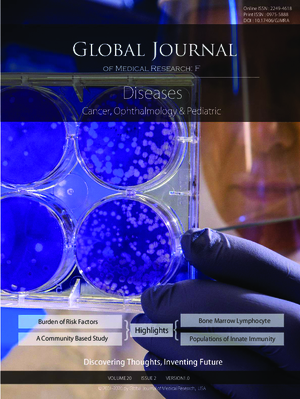
GJMR-F Diseases: Volume 20 Issue F2

-

GJMR-B Pharma, Drug Discovery, Toxicology and Medicine: Volume 20 Issue B2
Vol. 20 No. B2 (2020) -

GJMR-K Interdisciplinary: Volume 20 Issue K2
Vol. 20 No. K2 (2020) -

GJMR-G Veterinary Science and Veterinary Medicine: Volume 20 Issue G1
Vol. 20 No. G1 (2020) -

GJMR-I Surgeries and Cardiovascular System: Volume 20 Issue I1
Vol. 20 No. I1 (2020) -
GJMR-F Diseases: Volume 20 Issue F2
Vol. 20 No. F2 (2020) -

GJMR-B Pharma, Drug Discovery, Toxicology and Medicine: Volume 20 Issue B1
Vol. 20 No. B1 (2020) -

GJMR-K Interdisciplinary: Volume 20 Issue K1
Vol. 20 No. K1 (2020) -

GJMR-D Radiology, Diagnostic Imaging and Instrumentation: Volume 20 Issue D1
Vol. 20 No. D1 (2020) -

GJMR-J Dentistry and Otolaryngology: Volume 20 Issue J2
Vol. 20 No. J2 (2020) -

GJMR-F Diseases: Volume 20 Issue F1
Vol. 20 No. F1 (2020) -

GJMR-H Orthopedic and Musculoskeletal System: Volume 20 Issue H1
Vol. 20 No. H1 (2020) -

GJMR-E Gynecology and Obstetrics: Volume 20 Issue E2
Vol. 20 No. E2 (2020) -

GJMR-A Interdisciplinary: Volume 20 Issue A1
Vol. 20 No. A1 (2020) -

GJMR-J Dentistry and Otolaryngology: Volume 20 Issue J1
Vol. 20 No. J1 (2020) -

GJMR-C Microbiology and Pathology: Volume 20 Issue C1
Vol. 20 No. C1 (2020) -

GJMR-L Surgeries and Cardiovascular System: Volume 20 Issue L1
Vol. 20 No. L1 (2020) -

GJMR-E Gynecology and Obstetrics: Volume 20 Issue E1
Vol. 20 No. E1 (2020) -

GJMR-H Orthopedic and Musculoskeletal System: Volume 19 Issue H3
Vol. 19 No. H3 (2019) -

GJMR-J Dentistry and Otolaryngology: Volume 19 Issue J5
Vol. 19 No. J5 (2019) -

GJMR-B Pharma, Drug Discovery, Toxicology and Medicine: Volume 19 Issue B3
Vol. 19 No. B3 (2019) -

GJMR-E Gynecology and Obstetrics: Volume 19 Issue E4
Vol. 19 No. E4 (2019) -

GJMR-J Dentistry and Otolaryngology: Volume 19 Issue J4
Vol. 19 No. J4 (2019) -

GJMR-I Surgeries and Cardiovascular System: Volume 19 Issue I2
Vol. 19 No. I2 (2019) -

GJMR-D Radiology, Diagnostic Imaging and Instrumentation: Volume 19 Issue D2
Vol. 19 No. D2 (2019) -

GJMR-E Gynecology and Obstetrics: Volume 19 Issue E3
Vol. 19 No. E3 (2019)